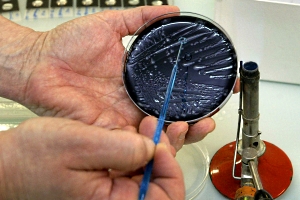

Бактерии в трубах
Роспотребнадзор выявил наличие ДНК легионеллы в пробе горячей воды, взятой в сетях горячего водоснабжения одного из микрорайонов Екатеринбурга
Екатеринбург. 22 сентября. INTERFAX.RU - Управление Роспотребнадзора по Свердловской области выявило наличие ДНК легионеллы в пробе горячей воды, взятой в сетях горячего водоснабжения микрорайона Химмаш в Екатеринбурге.
Как отмечается в сообщении пресс-службы управления, опасная бактерия найдена в пробе, взятой из распределительной сети по ул. Инженерная, 31. В настоящее время проводится бактериологическое подтверждение наличия легионеллы и определение ее концентрации в отобранной пробе для определения степени эпидемической опасности горячей воды. ЕМУП "Тепловые сети" проводят промывку и дезинфекцию тепловых сетей. Решение о подаче воды населению будет принято после завершения лабораторных исследований.
"Окончательный вывод о наличии угрозы здоровью населения может быть сделан только после завершения лабораторных исследований бактериологическим методом. Ориентировочный срок готовности результатов лабораторных исследований - 26 сентября", - говорится в сообщении.
Как сообщалось, пробы горячей воды, взятые ЕМУП "Тепловые сети" 19 сентября, показали наличие ДНК легионеллы, в связи с чем предприятие прекратило забор воды из тепловых сетей на нужды горячего водоснабжения микрорайона до получения официального протокола лабораторных испытаний на подтверждение наличия в воде бактерии.
Прокуратура Чкаловского района Екатеринбурга организовала проверку по факту обнаружения опасной бактерии.
Сети горячего водоснабжения Химмаша находятся в зоне теплоснабжения котельной ОАО "Уралхиммаш". Там сложившуюся ситуацию назвали провокацией в их адрес со стороны "Тепловых сетей". ЕМУП задолжало предприятию порядка 109 млн руб., впоследствии руководство компаний договорилось о снижении долга до 60 млн рублей. После срочного погашения задолженности котельная "Уралхиммаша" должна была начать полную подачу горячей воды в дома микрорайона Химмаш.
"Администрация предприятия рассматривает заявления ЕМУП "Тепловые сети" об обнаружении ДНК легионелл как шантаж, чтобы не оплачивать долги за оказанные услуги, и скрыть свою неготовность к отопительному сезону", - сказано в сообщении "Уралхиммаша". Компания заявляла раннее, что обратится в прокуратуру с заявлением о рассмотрении заявления "Тепловых сетей" как информации порочащие репутацию предприятия.
Напомним, летом 2007 г. в Верхней Пышме Свердловской области скончались пять человек, клинически диагноз "легионеллезная пневмония" был подтвержден у 149 человек. По версии следствия, причиной заболевания людей стала горячая вода из крана, включенная в Верхней Пышме после "опрессовок".
По данным медиков, возбудитель "пневмонии легионеров" - Legionella Pneumophila - впервые был зафиксирован 30 лет назад в США и встречается относительно редко. По данным СМИ, в России в 2003 и в 2004 гг. зафиксировано 18 случаев легионеллеза. В 2005 г. всего описано 26 случаев легионеллеза в России. В 2004 г. по 7 случаев легионеллеза отмечалось в Воронежской области и Санкт-Петербурге. В 2005 г. из всех зарегистрированных случаев заболевания 3 отмечалось в Воронежской области, 12 случаев – в Санкт-Петербурге, по 2 в Ставропольском крае и Волгоградской области, 7 случаев в Мордовии.
В начале сентября Роспотребнадзор сообщил о выявлении случаев легионеллеза среди туристов на курорте в Италии и в связи с этим обратил повышенное внимание на возвращающихся оттуда отдыхающих. "По данным Всемирной организации здравоохранения от 31 августа, 25 августа были зарегистрированы 9 лабораторно подтвержденных случаев болезни легионеров среди туристов, отдыхающих в Италии в Lazise, на озере Garda", - заявил тогда глава Роспотребнадзора Геннадий Онищенко. Он просил организовать взаимодействие с органами управления здравоохранения в субъектах РФ "с целью своевременного выявления случаев заболевания" и при сборе анамнеза у больных с симптомами пневмонии и ОРВИ, обращать внимание на факт пребывания их в Италии, а в случае "подтверждения данного факта в обязательном порядке проводить лабораторные исследования на легионеллез".
















